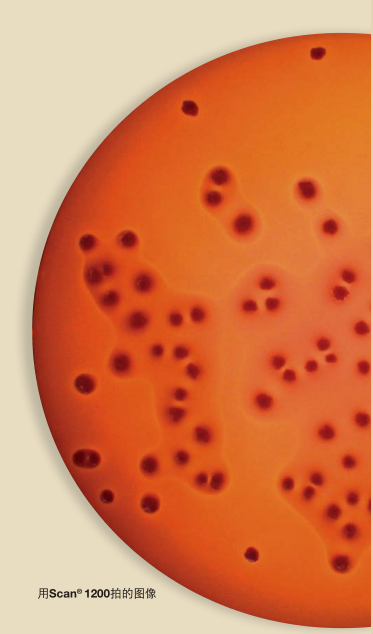

Scan ® 自动菌落计数及抑菌圈分析仪器
法国 interscience
为微生物的分析而设计、生产
• 从样品制备到样品分析
• 产于法国
• 凭借着其创新性和产品的可靠性成为R&D的引领者
• 遍布全球的分销网络,直接递送
计数参数
Scan® 菌落计数
高质量的分析,全面的追踪
Scan ® 300, Scan ® 500 & Scan ® 1200
高技术含量的全自动菌落计数器
配有数字照相机和高科技软件, Scan ® 可通过USB插口连接电脑。
在少于1s内计数培养皿上所有菌落,提供全面,快速,精确,可追溯性结果。
样品的分析
• 食品分析
• 总细菌分析:
计数菌落总数,需氧菌和厌氧菌,乳酸杆菌......
• 致病性细菌的研究
• 环境的研究
• 制药分析
• 医药分析
• 化妆品的分析
抑菌圈分析
• 制药工业、医药研究
(抗菌谱、对致病性微生物的敏感性测试、医药诊断)
• 食品领域
乳酸菌发酵和乳制品成份行业的测试
-
全自动菌落计数
-
抑菌圈的读取 *
-
数据的跟踪及详细的报告
高性能
> 多种培养基的菌落计数
> 可计数不同颜色的菌落
(在同一培养皿上达到7种不同的颜色)
> 抑菌圈的测试
实况影像
> 适合任何类型的培养皿:
自动调整亮度及对比度
> 高清晰度的颜色图像
> 每一个菌落都会用叉号标记
> 变焦:Scan ® 1200可达28倍
瞬间得到结果
> 在1秒内能够检测到1000个菌落
> 在5分钟内可计数30个培养皿
(在预先调整的情况下)
> 可重现标准化结果
> Scan ® 结果:瞬间性、全自动
使用方便
单击即可计数 <
所有功能只需一个窗口 <
定制参数:日期、用户名、项目 <
Darkfi eld 技术
呈现每一个菌落 <
优化的亮度和对比率 <
长寿的LED光源 <
六种光源和背景的组合 <
追踪能力及报告
自动收集和打印数据,图片,备注及结果 <
以Excel TM 、PDF、JPEG、BMP的形式输出结果 <
条形码的读取 <
连接到LIMS网络 <
高效\省时
瞬间得到结果
由于培养皿的实况影像能够在计算机上呈现出来,计数多与1000CFU\秒,每一个被计数的菌落都会被标记,其结果都会被自动地保存。
世界唯一的无设置操作
在列表中选择预设培养基参数
也可读:
- Sanita-kun TM : AC, CC, EC/CC, SA
- Petrifi lm TM : AC, ETB, CC, EC/CC, EC
- Compact Dry TM : TC, CF, EC, ETB
高性能的菌落计数
Scan ® 适合任何类型的菌落,Scan ® 1200 可计数的最小菌落为0.05mm, Scan ® 500 和Scan ® 300 可计数的最小菌落为0.1mm,菌落计数器能自动分离融合性的菌落,可以创造多边形区域以便排除培养基的缺陷及空气泡。你也可以
手工增加或移动菌落,每一个改变都会自动地保存在报告中。
颜色的识别及显色培养基
Scan ® 500及Scan ® 1200均可读取显色培养基并通过颜色来区分不同的菌落:即使同一个培养皿上有7种不同颜色的菌落,颜色选择可以直接从细菌的颜色中选,可调节颜色灵敏度。
Scan® : 3种适合你需求的模型:
Scan ® 300
基本型
货号 436 300
6种灯光和背景组合
• 自动移动背景颜色
• 亮度,对比度和灵敏度由软件自动优化
• LED灯使用寿命长
• CMOS 彩色照相机,28次变焦,M12镜头
• 所选菌落最小规格:0.1毫米
Scan ® 500
高效
货号 436 000
6种灯光和背景组合
• 自动移动背景颜色
• 亮度,对比度和灵敏度由软件自动优化
• LED灯使用寿命长
• CMOS 彩色照相机,28次变焦,M12镜头
• 所选菌落最小规格:0.1毫米
• 在一个培养皿上检测和计数
7种不同颜色菌落
• EUCAST,CA-SFM, CLSI 及可编程数据
库分析抑菌圈
Scan ® 1200
高分辨率
货号 437 000
6种灯光和背景组合
• 自动移动背景颜色
• 亮度,对比度和灵敏度由软件自动优化
• LED灯使用寿命长
• HD 彩色照相机,28倍变焦, HD日本镜头
• 所选菌落最小规格:0.05毫米
• 在一个培养皿上检测和计数
7种不同颜色菌落
• EUCAST,CA-SFM, CLSI 及可编程数据
库分析抑菌圈
• PetriFilm™测试纸,Compact Dry™
测试纸, Sanita-kun™测试纸, 滤膜
分析
抑菌圈分析
高性能及其灵活性
Scan ® 500及Scan ® 1200能够高效率的工作,因为你可以
创建和编辑一系列的抗生素,这对于常规性的分析很有
用处
用Scan ® 1200测量抑菌圈可以确保分析和诊断可靠性和
重现性
• 快速检测:点击一下,即刻检测可达8种抗生素的敏感性
• 抑菌圈可以人工增加或删除
医药学分析
抑菌圈测量能够让你在微生物领域测试抗生素的功效,
从而快速诊断,准确地选择一个适当的抗生素对症下
药。 Scan ® 有一个内置的抗生素数据库。数据库涵盖了
法国微生物学(CA-SFM),欧洲药敏测试委员会(EUCAST)
以及临床和实验室标准协会(CLSI)的各项标准。通过检测
可以得出细菌对抗生素的敏感性。这个数据库是完全可
编辑的。
制药学分析
在制药工业当中, Scan ® 能够使你在生产过程中通过测试
抑菌圈进而测试抗生素的质量,培养基扩散的测量能够让
你评估抗生素的作用。
易于使用
高清晰实况影像
此参数使您完全得控制菌落计数
最佳可视化
良好的菌落视觉与”Dark Field”技术是无法比拟的(双
斜切线和交叉对光反射),高清晰度的实况影像及图象
的自动优化(亮度、对比度、敏感度)。你也可以利用
数码变焦检查一些主要区域。
使用方便
所有Scan ® 的功能都集中在一个简单的窗口,单击
一次即可以计数菌落。
Scan ® 简单操作(视屏,设置,结果)可以快速调整
并保存。
Scan ® 软件有7种语言( 英文,法语,中文,俄罗
斯语,日语,西班牙语, 德语 )保证了其可靠性
并有规律地更新。您可以方便、快捷地使用
Scan,不需要过多的训练及要求。

快速交流全程可追溯性
结果的协调
使用Scan ® 可获得更可靠的分析,并有益于团队成员得出
统一的结果。你可以保存多种参数设置,并且可以根据
培养基以及琼脂的类型自定义参数。
自动存档数据,照片,注释和结果确保可追溯性
打印结果
可以导出数据到电脑,存档为 Excel TM ,PDF,SCA或BIO格式。也可以从照相机中以JPEG,PNG,BMP格式导出图片
结果的重现性
自动计数是分析规律和标准化的一种保证,也是确保结果精确及可靠的关键。结果的重现性是对用户在不论什么时候、什么情况下的一种保证。
对菌落计数器一项科学研究表明其具有98%的精确性可提供参考
内部可追溯性
得益于LIMS的连接及条形码的读取,被计数的图像可以保存和追踪。图像在任何时间都可以访问并重新计数。
保护您的会话
会话会被安全密钥(每个操作者一个)所保护,不改变每一个被保存的计数。Scan ® 使用遵循CFR21第11部分:系统安全性操作控制及文件管理。

外部可追溯性
Adobe
PDF
JPEG
JPG
Excel™
XLS
Scan ® 软件提供简单及快速结果输出功能
Plate & Count System®with dataLink ™
接种与计数系统,提供给你快捷、安全及全面跟踪的结果得益于全自动接种仪和菌落计数器。
增强你的实验室能力
-
难以置信的节约: 可节省75%的耗材及空间
-
快速: 整个接种周期仅需25s且一键计数
-
可靠: 98%的结果重现性
-
datalink™系统使您得到完整可追溯性:自动可保存数据及做出报表
其中包括:
• 全自动接种仪、
• 全自动菌落计数器
• dataLink™: 可追溯系统
接种和计数培养皿
一个培养皿可计数30到1x10 12 CFU/mL
easySpiral ® 在8秒内自动接种样品:一个培养皿可计数30到1x10 12 CFU/mL,无需预先稀释。当样品接种培养后,
就可以使用自动菌落计数器计数。计数结果立即显示并保存。
可节省75%的耗材
easySpiral ® 和 Scan ® 保证了分析的规律性以及标准化,节省时间、耗
材以及操作空间达 75% 。